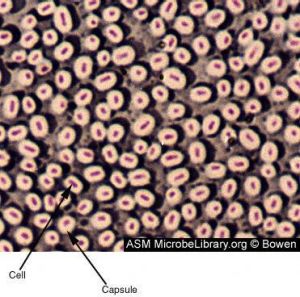
細胞壁

基本簡介
細胞壁
細胞壁細菌細胞壁主要成分是肽聚糖(peptidoglycan),又稱粘肽(mucopetide)。細胞壁的機械強度有賴於肽聚糖的存在。合成肽聚糖是原核生物特有的能力。肽聚糖是由n-乙醯葡萄糖胺和n-乙醯胞酸兩種氨基糖經β-1.4糖苷鍵連線間隔排列形成的多糖支架。在n-乙醯胞壁酸分子上連線四肽側鏈,肽鏈之間再由肽橋或肽鏈聯繫起來,組成一個機械性很強的網狀結構。各種細菌細胞壁的肽聚糖支架均相同,在四肽側鏈的組成及其連線方式隨菌種而異。
細菌細胞壁堅韌而富有彈性,保護細菌抵抗低滲環境,承受世界盃內的5~25個大氣的滲透壓,並使細菌在低滲的環境下細胞不易破裂;細胞壁對維持細菌的固有形態起重要作用;可允許水分及直徑小於1nm的可溶性小分子自由通過,與物質交換有關;細胞壁上帶有多種抗原決定簇,決定了細菌菌體的抗原性。
結構介紹
 細胞壁
細胞壁細胞壁的結構一般分下列三層
1.胞間層胞間層是在細胞分裂產生新細胞時形成的,是相鄰兩個細胞間所共有的一層薄膜。它的主要成分是膠粒柔軟的果膠質。胞間層既將相鄰細胞粘連在一起,又可緩衝細胞間的擠壓,也不會阻礙細胞生長。
2.初生壁在細胞分裂末期胞間層形成後,原生質體就必泌纖維素、半纖維素和少量的果膠質,添加在胞間層上,構成細胞的初生壁。初生壁有彈性,能隨著細胞的生長不斷增加面積。這種在細胞生長時形成的細胞壁,叫做初生壁,植物細胞都有初生壁。
3.次生壁細胞停止生長後,原生質體仍繼續分泌纖維素和其他物質,增添在初生壁內方,使細胞壁加厚,這部分加厚的細胞壁叫次生壁。次生壁添加在初生壁裡面,次生壁越厚,壁內的細胞腔就越小。次生壁只在植物體的部分細胞中有。厚壁的纖維細胞、石細胞、管胞和導管等有明顯增厚的次生壁。
細胞壁的主要組成成分是纖維素,它形成細胞壁的框架,內含其他物質。在電子顯微鏡下看到,這種框架由一層層纖維素微絲,簡稱微纖絲組成的,每一層微纖絲基本上是平行排列,每添加一層,微纖絲排列的方位就不同,因此層與層之間微纖絲的排列交錯成網。微纖絲之間的空間通常被其他物質填充。
此外,在一些植物表皮細胞壁中,常有蠟質、角質、木栓質。在一些成熟和加厚的細胞壁中,常沉積木質素。在禾本科、木賊科植物的表皮細胞壁中含有矽。在真菌類的細胞壁中還有甲殼質。
細胞壁上有紋孔,是因為在細胞生長過程中,初生壁隨著細胞的生長而不斷伸展,但壁的增厚是不均勻的,形成了許多壁薄的區域,叫做初生紋孔場;細胞產生次生壁時,增厚也不均勻,一般在初生紋孔場的部位不再加厚,細胞壁上就形成紋孔的結構。相鄰細胞壁上的紋孔常對應地形成紋孔對。紋孔有單紋孔和具緣紋孔兩種。通常有許多胞間連絲從紋孔通過,胞間連絲又跟細胞質中的內質網連線,從而溝通細胞間的物質交流,有利於水分的運輸。因此,細胞壁上的紋孔是細胞間聯繫的通道,使整個植物體在生命活動中能成為有機的統一體。
新細胞壁的形成是在細胞分裂末期的赤道面上,分裂的母細胞先形成成膜體。在染色體分向兩極時,高爾基器分離出的小泡與微管集合在赤道面上成為細胞板。新的多糖物質沉積在細胞板上就逐漸形成胞間層。其後細胞內合成一些纖維素組成微纖絲沉積在胞間層的兩側,就出現了初生壁。當細胞成熟停止生長以後,一層層新的纖維素和半纖維素以及木質素陸續添加在初生壁上,就建成了次生壁。初生壁每添加一層,微纖維排列的方向就可不同(縱向或橫向),形成了不規則的交錯網狀,稱為多網生長。這樣加厚的結果,使整個植物體的機械支持有了基礎。
有人認為細胞壁發生的步驟有三:①在由高爾基器所產生的小泡中形成前體(壁的結構單位),隨著膜流的方向,逐步推進到細胞表面,經外排作用,放出前體;②放出的前體結合到一定的網狀物上;③在稠密的細胞壁上出現化學變化,轉換、變松和生長等現象,建成了細胞壁。上述這些化學組成在生長與發育過程中是不斷改變的。例如在剛出現的初生壁只有一些稀疏的微纖維附著在細胞板上,隨著生長繼續進行,纖維素的含量增加,而果膠質的合成則下降,次生壁在最幼年的形成層細胞,剛成熟的邊材和在樹桿中央的心材三者之間比較,果膠質含量比較恆定,但數量很少。半纖維素,纖維素和木質素的含量增加很大。如在槭樹中木質素在邊材中的含量比形成層細胞多90倍。
化學組成
細胞壁的化學組成是胞間層基本上是由果膠質組成,如果植物組織中的果膠質用果膠酶分解掉,細胞就會離散。初生壁是由水、半纖維素、果膠質、纖維素、蛋白質和脂類組成。胚芽鞘、莖、葉、毛等初生壁的各種成分的平均值見表。構成細胞壁的成分中,90%左右是多糖,10%左右是蛋白質、酶類以及脂肪酸。細胞壁中的多糖主要是纖維素、半纖維素和果膠類,它們是由葡萄糖、阿拉伯糖、半乳糖醛酸等聚合而成。次生細胞壁中還有大量木質素。
形成情況
 細胞壁
細胞壁可見,細胞壁的形成是在生活細胞分裂、成長以至分化的過程中逐步完成的。在細胞分裂以及新細胞壁形成時,除了有高爾基體、內質網和微管參與外,還有生長素和多種酶類的作用,而所有的活動又要靠線粒體來提供能量,這正體現了細胞內各部位相互配合來共同完成生命活動的特徵。
種類介紹
·細菌細胞壁
 細胞壁
細胞壁革蘭氏陽性菌的四肽側鏈胺基酸由d-丙-d-谷-r-l-賴-d-丙組成。初合成的肽鏈末端多一個d-丙氨酸殘基。肽橋是一條5個甘氨酸的肽鏈,交聯時一端與側鏈第三位上賴氨酸連線,另一端在轉肽酶的作用下,使另一條五肽側鏈末端d-丙氨酸脫去,而與側鏈第四位d-丙氨酸連線。從x光檢查可見肽聚糖的多糖鏈是一條較硬而又呈螺鏇狀捲曲的長桿,由於其呈螺鏇狀,連線在其上的肽鏈才伸向四方,使交聯受到一定了限制,只有鄰近的肽鏈才可交聯。但葡萄球菌的肽橋較長,有可塑性,使遠距離的肽鏈間也可交聯,交聯率達90%,形成堅固緻密的三維立本網狀結構。革蘭氏陰性大腸桿菌的四肽側鏈中第三位的胺基酸被二氨基庚二酸(dap)所取代,以肽鏈直接與相鄰四肽側鏈中的d-丙氨酸相連,且交聯率低,沒有五肽交聯橋,形成二維平面結構,所以其結構較革蘭氏陽性的葡萄球疏樺。
細菌細胞壁結構
凡能破壞肽聚糖結構或抑制其合成的物質,都能損傷細胞壁而使細菌變形或殺傷細菌,例如溶菌酶(lysozyme)能切斷肽聚糖中n-乙醯葡萄糖胺和n-乙醯胞壁酸之間的β-1.4糖苷鍵之間的聯苷鍵之間的聯結,破壞肽聚糖支架,引起細菌裂解。青黴素和頭孢菌素能與細菌競爭合成胞壁過程所需的轉肽酶,抑制四肽側鏈上d-丙氨酸與五肽橋之間的聯結,使細菌不能合成完整的細胞壁,可導致細菌死亡。人和動物細胞無細胞壁結構,亦無肽聚糖,故溶菌酶和青黴素對人體細胞均無毒性作用。除肽聚糖這一基本成份以外,革蘭氏陽性菌和革蘭氏陰性菌還各有其特殊結構的成分。
細菌細胞壁堅韌而富有彈性,保護細菌抵抗低滲環境,承受世界盃內的5~25個大氣的滲透壓,並使細菌在低滲的環境下細胞不易破裂;細胞壁對維持細菌的固有形態起重要作用;可允許水分及直徑小於1nm的可溶性小分子自由通過,與物質交換有關;細胞壁上帶有多種抗原決定簇,決定了細菌菌體的抗原性。
·酵母細胞壁
酵母細胞壁的厚度為0.1~0.3μm,重量占細胞乾重的18%~30%,主要由D-葡聚糖和D-甘露聚糖兩類多糖組成,含有少量的蛋白質、脂肪、礦物質。大約等量的葡聚糖和甘露聚糖占細胞壁乾重的85%。當細胞衰老後,細胞壁重量會增加一倍。它雖然有一定韌性,但其堅韌性使酵母保持特殊的形狀。其化學成分較特殊,主要由酵母纖維素組成,它的結構類似三明治。外層為甘露聚糖,約占細胞壁乾重的40%~45%。中間層是一層蛋白質分子,約占細胞壁乾重的10%。其中有些是以與細胞壁相結合的酶的形式存在。內層為葡聚糖。
酵母葡聚糖

酵母葡聚糖具有以下生理活性
1、活化並增強免疫系統。人體內具有很多自身免疫細胞,它們守護著人體的健康,使人體在受到外界刺激是能及時產生免疫應答,防禦外來入侵。β-1,3-葡聚糖是六價鍵結構,它的促有絲分裂活性可從多重角度協助免疫細胞發揮作用。包括增加天然殺傷細胞的活性和T細胞介導的細胞毒性、增強外周單核細胞的增殖應答產生分裂素,刺激釋放白介素以及誘導嗜中性粒細胞的吞噬作用。它的這些作用可以有效增強人體免疫系統,提高人體免疫力,使自身免疫系統達到最佳平衡狀態。
2、抗輻射作用。葡聚糖的抗輻射作用是促進造血機能的結果。顆粒葡聚糖給藥能增強血細胞的生成活性,包括粒細胞的生成、單核白細胞的生成和紅細胞的生成,從而導致更好地從致命劑量的輻射中得到恢復。
3、抗腫瘤作用。β-葡聚糖的抗腫瘤活性與巨噬細胞的功能有很大關係。巨噬細胞功能增強對抑瘤活性高,β-葡聚糖就是通過活化增強巨噬細胞來達到抑制腫瘤的效果的。特別是對於長期接受放療的患者,更能增強病人抵抗力。
4、抗炎作用。許多研究已經表明顆粒葡聚糖除了影響網狀內皮系統和免疫應答外,體內給藥大大地改善了宿主對各種由細菌、真菌、病毒和寄生蟲引起的感染性疾病的抵抗能力。
5、幫助身體組織結構再生、重建、修復,促進傷口癒合。臨床證實,β-1,3-D葡聚糖使用在皮膚上,能增加皮膚彈性,並柔嫩白皙,提高膠原蛋白和彈力纖維素的合成,供應多種細胞生長因子,使皺紋消除,肌膚潔淨,並修復敏感現象。
6、調節胃腸功能,作為膳食纖維來發揮作用。它可以促進腸道蠕動,吸收腸內有害物質,促進腸內有用菌的活化。從而改善因食物纖維攝入不足引起的便秘,胃腸虛弱引起的消化不良。
功能介紹
對於細胞壁的功能,目前較肯定的有以下幾個方面:
1、維持細胞形狀,控制細胞生長細胞壁增加了細胞的機械強度,並承受著內部原生質體由於液泡吸水而產生的膨壓,從而使細胞具有一定的形狀,這不僅有保護原生質體的作用,而且
維持了器官與植株的固有形態。另外,細胞壁控制著細胞的生長,因為細胞要擴大和伸長的前提是要使細胞壁松馳和不可逆伸展。次生細胞壁、初生細胞壁和中膠層結構示意圖(Hopkins 1995)
2、物質運輸與信息傳遞細胞壁允許離子、多糖等小分子和低分子量的蛋白質通過,而將大分子或微生物等阻於其外。因此,細胞壁參與了物質運輸、降低蒸騰作用、防止水分損失(次生壁、表面的蠟質等)、植物水勢調節等一系列生理活動。細胞壁上紋孔或胞間連絲的大小受細胞生理年齡和代謝活動強弱的影響,故細胞壁對細胞間物質的運輸具有調節作用。另外,細胞壁也是化學信號(激素、生長調節劑等)、物理信號(電波、壓力等)傳遞的介質與通路。
3、防禦與抗性細胞壁中一些寡糖片段能誘導植保素(phytoalexin)的形成,它們還對其它生理過程有調節作用,這種具有調節活性的寡糖片斷稱為寡糖素(oligosaccharin)。將一種庚葡萄糖苷寡糖素施加於大豆細胞時,會使負責合成抑制黴菌生長的抗菌素的基因活化而產生抗菌素。多種寡糖素的功能複雜多樣,如有的作為蛋白酶抑制劑誘導因子,在植物抵抗病蟲害中起作用;有的寡糖素可使植物產生過敏性死亡,使得病原物不能進一步擴散;還有的寡糖素參與調控植物的形態建成。細胞壁中的伸展蛋白除了作為結構成分外,還有防病抗逆的功能。如黃瓜抗性品種感染一種黴菌後,其細胞壁中羥脯氨酸的含量比敏感品種增加得快。
4、其他功能細胞壁中的酶類廣泛參與細胞壁高分子的合成、轉移、水解、細胞外物質輸送到細胞內以及防禦作用等。
研究發現,細胞壁還參與了植物與根瘤菌共生固氮的相互識別作用,此外,細胞壁中的多聚半乳糖醛酸酶和凝集素還可能參與了砧木和接穗嫁接過程中的識別反應。應當指出的是,並非所有細胞的細胞壁都具有上述功能,每一類細胞的細胞壁功能都是由其特定的組成和結構決定的。
生物化學術語(一)
| 我們學習了很多的生物化學的專業術語。現在,我把它們都整理在一起,可以使我們更加全面、完整的學習,認識,了解它們。 |

